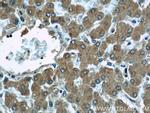
MAGT1 Antibody in Immunohistochemistry (Paraffin) (IHC (P))

Search
Proteintech
MAGT1 Polyclonal Antibody
{{$productOrderCtrl.translations['antibody.pdp.commerceCard.promotion.promotions']}}
{{$productOrderCtrl.translations['antibody.pdp.commerceCard.promotion.viewpromo']}}
{{$productOrderCtrl.translations['antibody.pdp.commerceCard.promotion.promocode']}}: {{promo.promoCode}} {{promo.promoTitle}} {{promo.promoDescription}}. {{$productOrderCtrl.translations['antibody.pdp.commerceCard.promotion.learnmore']}}
产品信息
17430-1-AP
种属反应
已发表种属
宿主/亚型
分类
类型
抗原
偶联物
形式
浓度
规格
纯化类型
保存液
内含物
保存条件
运输条件
产品详细信息
Immunogen sequence: KKEMVLSEK VSQLMEWTNK RPVIRMNGDK FRRLVKAPPR NYSVIVMFTA LQLHRQCVVC KQADEEFQIL ANSWRYSSAF TNRIFFAMVD FDEGSDVFQM LNMNSAPTFI NFPAKGKPKR GDTYELQVRG FSAEQIARWI ADRTDVNIRV IR (32-182 aa encoded by BC060842)
靶标信息
MAGT1 encodes a magnesium cation transporter protein that localizes to the cell membrane. This protein also associates with N-oligosaccharyl transferase and therefore may have a role in N-glycosylation. Mutations in this gene cause mental retardation X-linked type 95 (MRX95). This gene may have multiple in-frame translation initiation sites, one of which would encode a shorter protein with an N-terminus containing a signal peptide at amino acids 1-29.
仅用于科研。不用于诊断过程。未经明确授权不得转售。
生物信息学
蛋白别名: Dolichyl-diphosphooligosaccharide--protein glycosyltransferase subunit MAGT1; IAP; Implantation-associated protein; Magnesium transporter protein 1; MagT1; Mg2+ transporter; Oligosaccharyl transferase subunit MAGT1; oligosaccharyltransferase 3 homolog B; unnamed protein product
基因别名: 2410001C15Rik; 2610529C04Rik; 2810482I07Rik; bA217H1.1; CDG1CC; IAG2; IAP; MAGT1; MRX95; OST3B; PRO0756; PSEC0084; SLC58A1; UNQ628/PRO1244; XMEN
UniProt ID: (Human) Q9H0U3, (Rat) O35777, (Mouse) Q9CQY5
Entrez Gene ID: (Human) 84061, (Rat) 116967, (Mouse) 67075